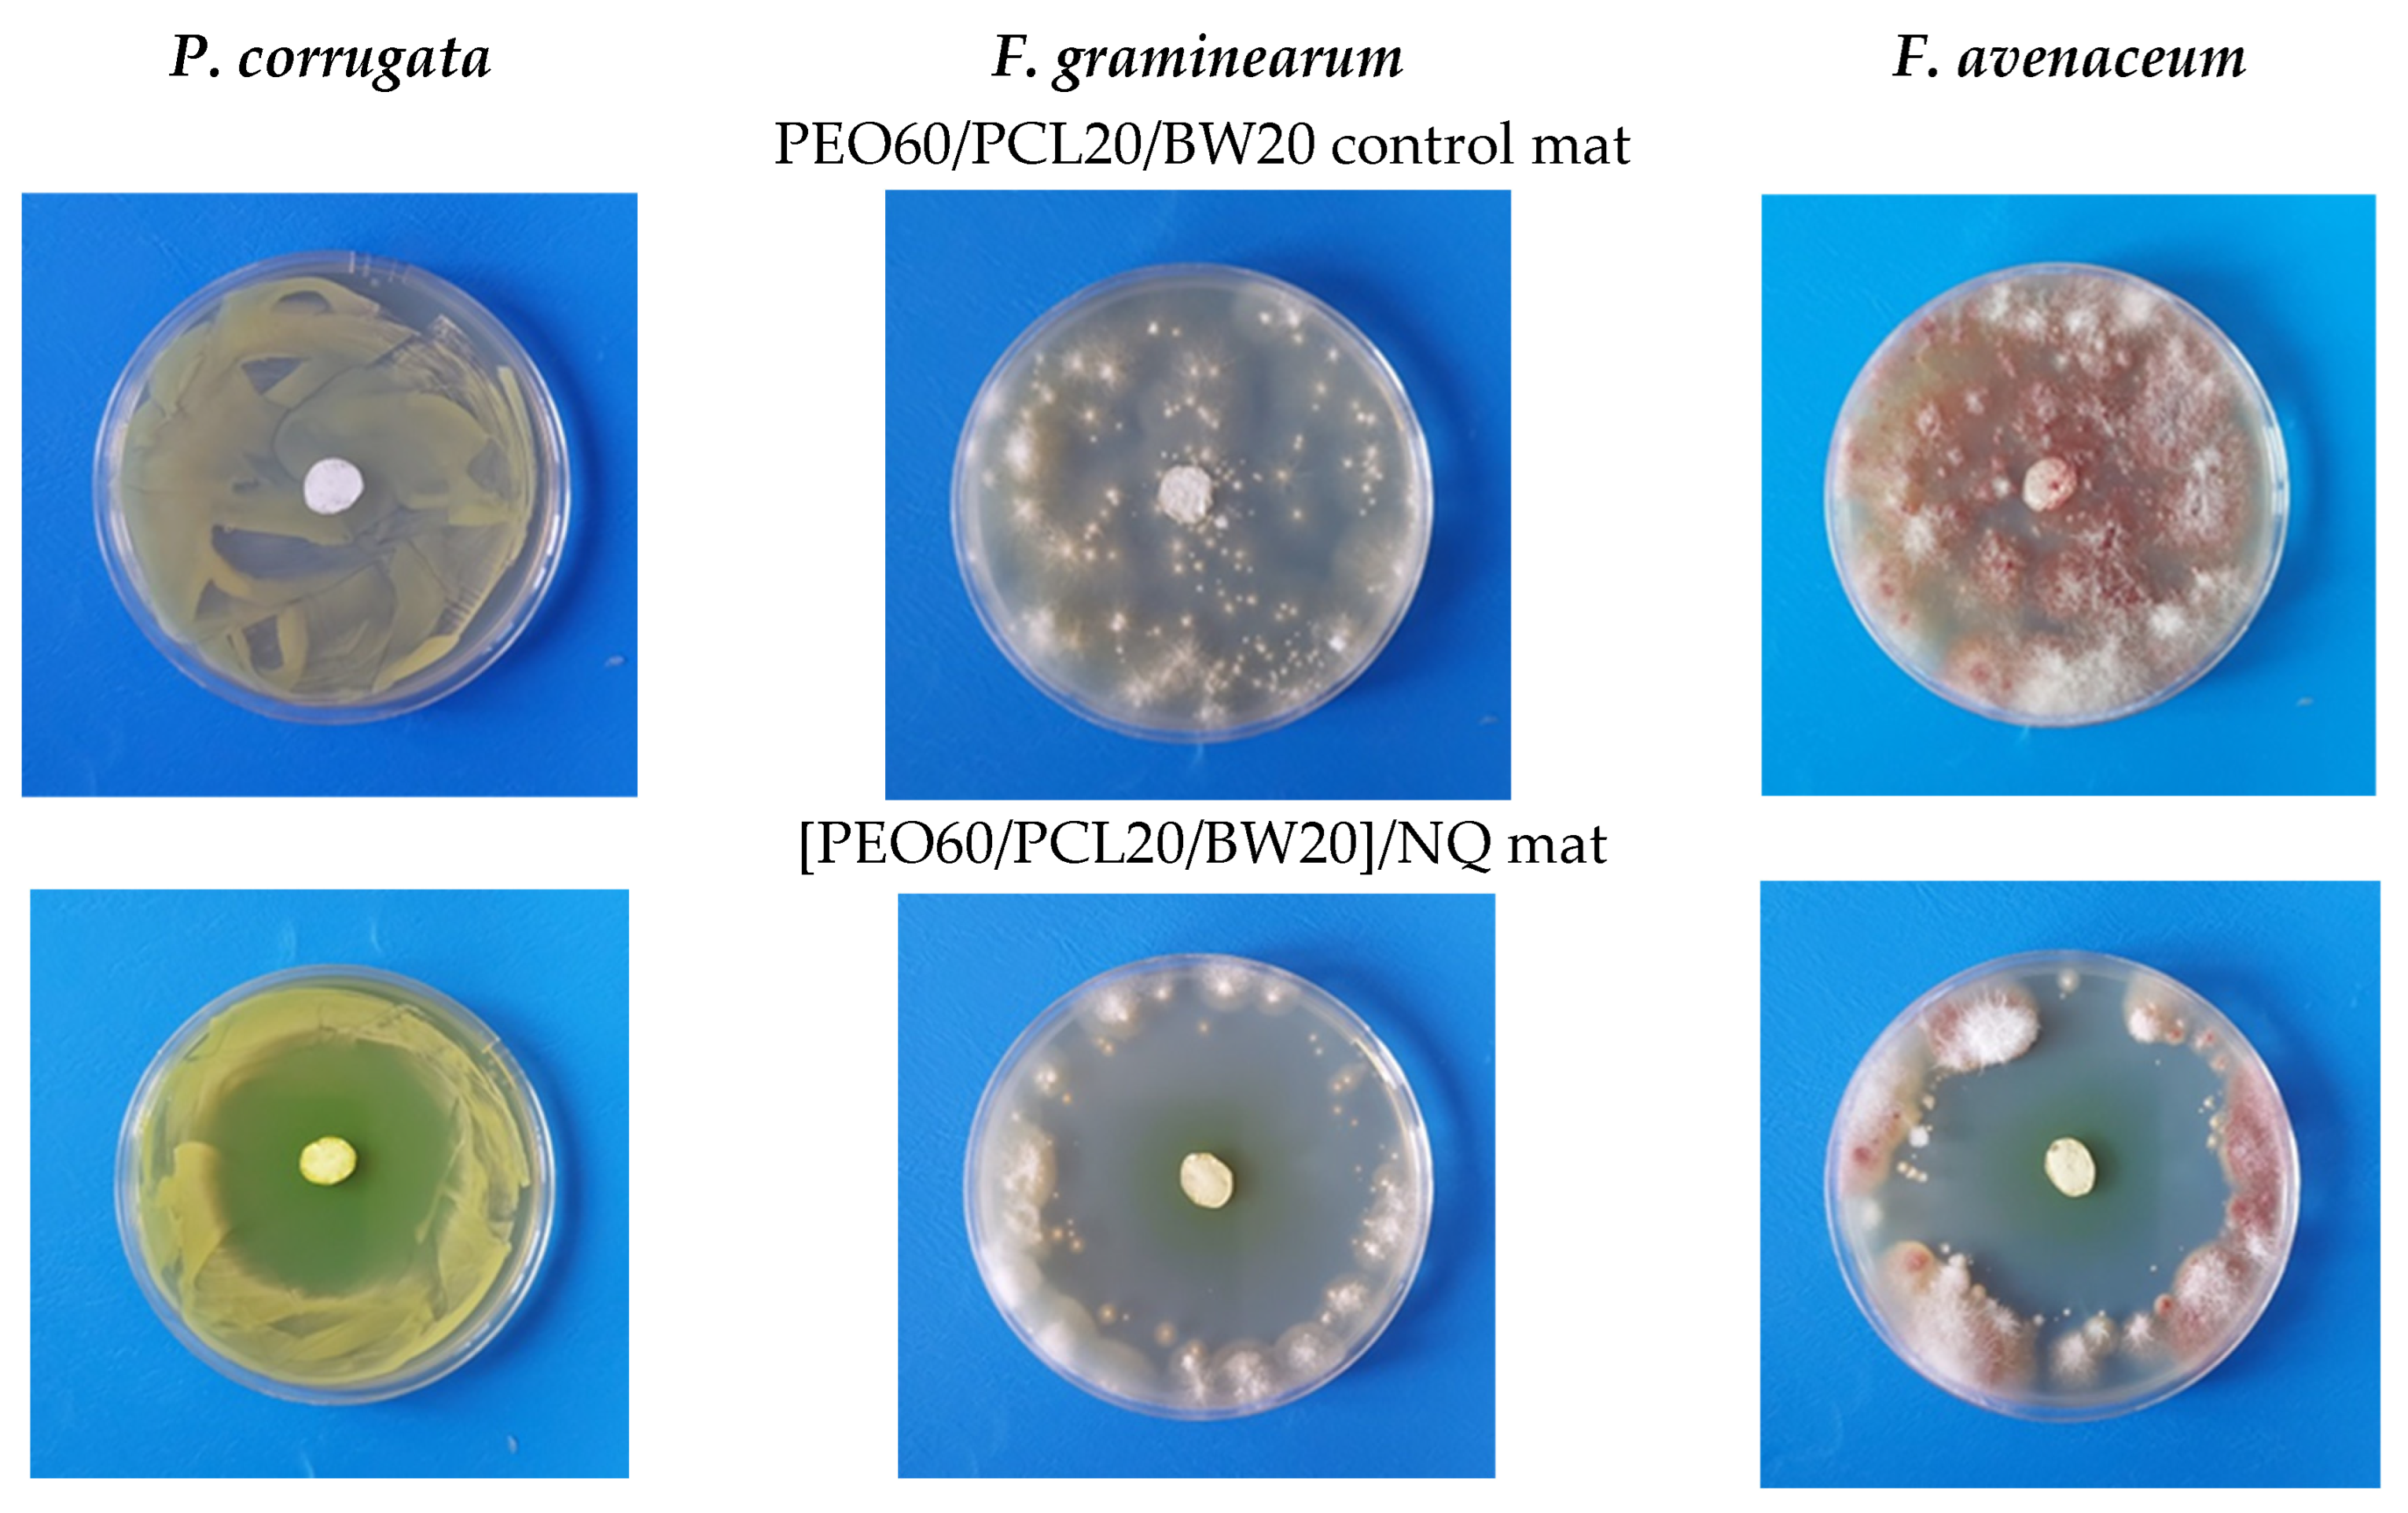
Materials 16 04882 g004

Electrospun Fibers of Biocompatible and Biodegradable Polyesters, Poly(Ethylene Oxide) and Beeswax with Anti-Bacterial and Anti-Fungal Activities
Abstract
1. Introduction
2. Materials and Methods
2.1. Materials
2.2. Preparation and Characterization of Electrospun Fibrous Materials from PEO/BW/NQ, PEO/PLA/BW/NQ, PEO/PCL/BW/NQ u PEO/PLA/BW/CQ
2.3. In Vitro Assessment of the Behavior of Electrospun Materials in Contact with Phytopathogenic and Beneficial Microorganisms
3. Results and Discussion
3.1. Composition, Morphology and Structural Peculiarities of PEO/BW/NQ, PEO/PLA/BW/NQ, PEO/PCL/BW/NQ and PEO/PLA/BW/CQ Fibers
3.2. Assessment of the Behavior of the Electrospun Materials in Contact with Phytopathogenic and Beneficial Microorganisms
3.2.1. Assessment of the Behavior of the Electrospun Materials in Contact with Phytopathogenic Bacteria and Fungi
3.2.2. Assessment of the Behavior of the Electrospun Materials in Contact with Beneficial Bacteria and Fungi
4. Conclusions
Supplementary Materials
Author Contributions
Funding
Institutional Review Board Statement
Informed Consent Statement
Data Availability Statement
Acknowledgments
Conflicts of Interest
References
- Xue, J.; Wu, T.; Dai, Y.; Xia, Y. Electrospinning and electrospun nanofibers: Methods, materials, and applications. Chem. Rev. 2019, 119, 5298–5415. [Google Scholar] [CrossRef] [PubMed]
- Noruzi, M. Electrospun nanofibres in agriculture and the food industry: A review. J. Sci. Food Agric. 2016, 96, 4663–4678. [Google Scholar] [CrossRef] [PubMed]
- Meraz-Dávila, S.; Pérez-García, C.E.; Feregrino-Perez, A.A. Challenges and advantages of electrospun nanofibers in agriculture: A review. Mater. Res. Express 2021, 8, 042001. [Google Scholar] [CrossRef]
- Pirzada, T.; Farias, B.V.; Mathew, R.; Guenther, R.H.; Byrd, M.V.; Sit, T.L.; Pal, L.; Opperman, C.H.; Khan, S.A. Recent advances in biodegradable matrices for active ingredient release in crop protection: Towards attaining sustainability in agriculture. Curr. Opin. Colloid Interface Sci. 2020, 48, 121–136. [Google Scholar] [CrossRef]
- Badgar, K.; Abdalla, N.; El-Ramady, H.; Prokisch, J. Sustainable Applications of Nanofibers in Agriculture and Water Treatment: A Review. Sustainability 2022, 14, 464. [Google Scholar] [CrossRef]
- Chakkalakkal, N.D.; Thomas, M.; Chittillapilly, P.S.; Sujith, A.; Anjali, P.D. Electrospun polymer nanocomposite membrane as a promising seed coat for controlled release of agrichemicals and improved germination: Towards a better agricultural prospect. J. Clean. Prod. 2022, 377, 134479. [Google Scholar] [CrossRef]
- Cherdtrakulkiat, R.; Boonpangrak, S.; Sinthupoom, N.; Prachayasittikul, S.; Ruchirawat, S.; Prachayasittikul, V. Derivatives (halogen, nitro and amino) of 8-hydroxyquinoline with highly potent antimicrobial and antioxidant activities. Biochem. Biophys. Rep. 2016, 6, 135–141. [Google Scholar] [CrossRef]
- Abouelhassan, Y.; Yang, Q.; Yousaf, H.; Nguyen, M.T.; Rolfe, M.; Schultz, G.S.; Huigens III, R.W. Nitroxoline: A broad-spectrum biofilm-eradicating agent against pathogenic bacteria. Int. J. Antimicrob. Agents 2017, 49, 247–251. [Google Scholar] [CrossRef]
- Pippi, B.; Reginatto, P.; Machado, G.R.M.; Bergamo, V.Z.; Lana, D.F.D.; Teixeira, M.L.; Franco, L.L.; Alves, R.J.; Andrade, S.F.; Fuentefria, A.M. Evaluation of 8-hydroxyquinoline derivatives as hits for antifungal drug design. Med. Mycol. 2017, 55, 763–773. [Google Scholar] [CrossRef]
- Yin, X.; Sun, A.; Lawoe, R.K.; Yang, G.; Liu, Y.; Shang, X.; Liu, H.; Yang, Y.; Zhu, J.; Huang, X. Synthesis and anti-phytopathogenic activity of 8- hydroxyquinoline derivatives. RSC Adv. 2019, 9, 30087–30099. [Google Scholar] [CrossRef]
- Kalita, N.B.; Hakkarainen, M. Integrating biodegradable polyesters in a circular economy. Curr. Opin. Green Sustain. Chem. 2023, 40, 100751. [Google Scholar] [CrossRef]
- Ma, L.; Deng, L.; Chen, J. Applications of poly(ethylene oxide) in controlled release tablet systems: A review. Drug Dev. Ind. Pharm. 2013, 40, 845–851. [Google Scholar] [CrossRef] [PubMed]
- Ruguo, Z.; Hua, Z.; Hong, Z.; Ying, F.; Kun, L.; Wenwen, Z. Thermal analysis of four insect waxes based on differential scanning calorimetry (DSC). Procedia Eng. 2011, 18, 101–106. [Google Scholar] [CrossRef]
- Janesch, J.; Arminger, B.; Gindl-Altmutter, W.; Hansmann, H. Superhydrophobic coatings on wood made of plant oil and natural wax. Prog. Org. Coat. 2020, 148, 105891. [Google Scholar] [CrossRef]
- Kyuchyuk, S.; Paneva, D.; Karashanova, D.; Markova, N.; Georgieva, A.; Toshkova, R.; Manolova, N.; Rashkov, I. Core-sheath-like poly(ethylene oxide)/beeswax composite fibers prepared by single-spinneret electrospinning. Antibacterial, antifungal, and antitumor activities. Macromol. Biosci. 2022, 22, 2200015. [Google Scholar] [CrossRef] [PubMed]
- Kyuchyuk, S.; Paneva, D.; Manolova, N.; Rashkov, I.; Karashanova, D.; Markova, N. Core/Double-Sheath Composite Fibers from poly(ethylene oxide), poly(L-lactide) and beeswax by single-spinneret electrospinning. Polymers 2022, 14, 5036. [Google Scholar] [CrossRef] [PubMed]
- Abdullah, M.F.; Nuge, T.; Andriyana, A.; Ang, B.C.; Muhamad, F. Core-shell fibers: Design, roles, and controllable release strategies in tissue engineering and drug delivery. Polymers 2019, 11, 2008. [Google Scholar] [CrossRef]
- Catara, V. Pseudomonas corrugata: Plant pathogen and/or biological resource? Mol. Plant Path. 2007, 8, 233–244. [Google Scholar] [CrossRef]
- Goswami, R.S.; Kistler, H.C. Heading for disaster: Fusarium graminearum on cereal crops. Mol. Plant Path. 2004, 5, 515–525. [Google Scholar] [CrossRef]
- Chen, Y.; Kistler, H.C.; Ma, Z. Fusarium graminearum trichothecene mycotoxins: Biosynthesis, regulation, and management. Annu. Rev. Phytopathol. 2019, 57, 15–39. [Google Scholar] [CrossRef]
- Inbaia, S.; Farooqi, A.; Ray, R.V. Aggressiveness and mycotoxin profile of Fusarium avenaceum isolates causing Fusarium seedling blight and Fusarium head blight in UK malting barley. Front. Plant Sci. 2023, 14, 1121553. [Google Scholar] [CrossRef] [PubMed]
- Anderson, A.J.; Kim, Y.C. Biopesticides produced by plant-probiotic Pseudomonas chlororaphis isolates. Crop Prot. 2018, 105, 62–69. [Google Scholar] [CrossRef]
- Ngalimat, M.S.; Yahaya, R.S.R.; Baharudin, M.M.A.; Yaminudin, S.M.; Karim, M.; Ahmad, S.A.; Sabri, S. A Review on the biotechnological applications of the operational group Bacillus amyloliquefaciens. Microorganisms 2021, 9, 614. [Google Scholar] [CrossRef] [PubMed]
- Tyskiewicz, R.; Nowak, A.; Ozimek, E.; Jaroszuk-Sciseł, J. Trichoderma: The current status of its application in agriculture for the biocontrol of fungal phytopathogens and stimulation of plant growth. Int. J. Mol. Sci. 2022, 23, 2329. [Google Scholar] [CrossRef]
- Kurata, M.; Tsunashima, Y. Polymer Handbook, 4th ed.; Brandrup, J., Immergut, E.H., Grulke, E.A., Eds.; John Wiley & Sons, Inc.: Hoboken, NJ, USA, 1999. [Google Scholar]
- Falcón-Piñeiro, A.; Remesal, E.; Noguera, M.; Ariza, J.J.; Guillamón, E.; Baños, A.; Navas-Cortes, J.A. Antifungal activity of propyl-propane-thiosulfinate (PTS) and propyl-propane-thiosulfonate (PTSO) from Allium cepa against Verticillium dahliae: In vitro and in planta assays. J. Fungi 2021, 7, 736. [Google Scholar] [CrossRef] [PubMed]
- Barakat, N.A.M.; Kanjwal, M.A.; Sheikh, F.A.; Kim, H.Y. Spider-net within the N6, PVA and PU electrospun nanofiber mats using salt addition: Novel strategy in the electrospinning process. Polymer 2009, 50, 4389–4396. [Google Scholar] [CrossRef]
- Penchev, H.; Paneva, D.; Manolova, N.; Rashkov, I. Hybrid nanofibrous yarns based on N-carboxyethylchitosan and silver nanoparticles with antibacterial activity prepared by self-bundling electrospinning. Carbohydr. Res. 2010, 345, 2374–2380. [Google Scholar] [CrossRef]

| Fibrous Material | Inhibition Zone, cm | ||
|---|---|---|---|
| P. corrugata | F. graminearum | F. avenaceum | |
| PEO/BW/NQ mat series | |||
| PEO70/BW30/NQ | 4.60 ± 0.14 | 4.40 ± 0.14 | 3.90 ± 0.13 |
| PEO60/BW40/NQ | 5.90 ± 0.12 | 4.50 ± 0.07 | 4.50 ± 0.13 |
| PEO/PLA/BW/NQ mat series | |||
| PEO70/PLA15/BW15/NQ | 5.50 ± 0.14 | 4.80 ± 0.40 | 4.70 ± 0.12 |
| PEO60/PLA20/BW20/NQ | 5.40 ± 0.12 | 4.90 ± 0.18 | 5.10 ± 0.17 |
| PEO60/PCL20/BW(20)/NQ mats | |||
| PEO60/PCL20/BW20/NQ | 5.30 ± 2.70 | 6.50 ± 5.80 | 6.00 ± 6.30 |
| PEO60/PLA20/BW20/CQ mats | |||
| PEO(60)/PLA(20)/BW(20)/CQ | 2.70 ± 0.10 | 1.70 ± 0.30 | 1.60 ± 0.30 |
| Fibrous Material | Inhibition Zone, cm | ||
|---|---|---|---|
| P. chlororaphis | B. amyloliquefaciens | T. asperellum | |
| PEO/BW/NQ mat series | |||
| PEO70/BW30/NQ | 4.00 ± 0.16 | 3.50 ± 0.04 | 5.00 ± 0.10 |
| PEO60/BW40/NQ | 4.20 ± 0.10 | 3.90 ± 0.10 | 5.70 ± 0.20 |
| PEO/PLA/BW/NQ mat series | |||
| PEO70/PLA15/BW15/NQ | 3.90 ± 0.10 | 3.90 ± 0.10 | 5.60 ± 0.15 |
| PEO60/PLA20/BW20/NQ | 4.30 ± 0.10 | 4.00 ± 0.10 | 6.00 ± 0.10 |
| PEO60/PCL20/BW(20)/NQ mats | |||
| PEO60/PCL20/BW20/NQ | 4.00 ± 1.10 | 4.00 ± 1.70 | 6.40 ± 0.10 |
| PEO60/PLA20/BW20/CQ mats | |||
| PEO(60)/PLA(20)/BW(20)/CQ | 1.40 ± 0.10 | 1.70 ± 0.10 | 1.30 ± 0.10 |
Disclaimer/Publisher’s Note: The statements, opinions and data contained in all publications are solely those of the individual author(s) and contributor(s) and not of MDPI and/or the editor(s). MDPI and/or the editor(s) disclaim responsibility for any injury to people or property resulting from any ideas, methods, instructions or products referred to in the content. |
© 2023 by the authors. Licensee MDPI, Basel, Switzerland. This article is an open access article distributed under the terms and conditions of the Creative Commons Attribution (CC BY) license (https://creativecommons.org/licenses/by/4.0/).
Share and Cite
Kyuchyuk, S.; Paneva, D.; Manolova, N.; Rashkov, I.; Karashanova, D.; Naydenov, M.; Markova, N. Electrospun Fibers of Biocompatible and Biodegradable Polyesters, Poly(Ethylene Oxide) and Beeswax with Anti-Bacterial and Anti-Fungal Activities. Materials 2023, 16, 4882. https://doi.org/10.3390/ma16134882
Kyuchyuk S, Paneva D, Manolova N, Rashkov I, Karashanova D, Naydenov M, Markova N. Electrospun Fibers of Biocompatible and Biodegradable Polyesters, Poly(Ethylene Oxide) and Beeswax with Anti-Bacterial and Anti-Fungal Activities. Materials. 2023; 16(13):4882. https://doi.org/10.3390/ma16134882
Chicago/Turabian StyleKyuchyuk, Selin, Dilyana Paneva, Nevena Manolova, Iliya Rashkov, Daniela Karashanova, Mladen Naydenov, and Nadya Markova. 2023. "Electrospun Fibers of Biocompatible and Biodegradable Polyesters, Poly(Ethylene Oxide) and Beeswax with Anti-Bacterial and Anti-Fungal Activities" Materials 16, no. 13: 4882. https://doi.org/10.3390/ma16134882
APA StyleKyuchyuk, S., Paneva, D., Manolova, N., Rashkov, I., Karashanova, D., Naydenov, M., & Markova, N. (2023). Electrospun Fibers of Biocompatible and Biodegradable Polyesters, Poly(Ethylene Oxide) and Beeswax with Anti-Bacterial and Anti-Fungal Activities. Materials, 16(13), 4882. https://doi.org/10.3390/ma16134882

